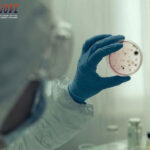
togel Online Terbaik, Agen Togel Terpercaya, Bandar Togel Terbaikel Online Terbaik, Agen Togel Terpercaya, Bandar Togel Terbaik

Cara Menang dan Tips Bermain Jurassic Kingdom Terbaru Jurassic Kingdom adalah permainan kasino online yang menarik dengan tema dunia prasejarah yang tenar di kalangan para pemain. Jika Anda inginkan sadar cara menang dan sebagian tips bermain Jurassic Kingdom terbaru, artikel ini bakal memberi tambahan saran yang berguna bagi Anda. Cara Menang dan Tips Bermain Jurassic […]
Category: Berita
“Rumah ‘Ajaib’ Selamat di Tengah Kebakaran Los Angeles”
“Rumah ‘Ajaib’ Selamat di Tengah Kebakaran Los Angeles” Judi Togel Online – Kebakaran hebat melanda Los Angeles dan melalap ribuan rumah. Namun tersedia satu tempat tinggal yang tampak berdiri sendiri, tak tersentuh, di tengah lautan reruntuhan tempat tinggal di sekitarnya. Rumah mewah seharga USD 9 juta di Malibu itu milik David Steiner, seorang pensiunan perusahaan […]
China Buka Suara ke WHO soal Gaduh Kenaikan Kasus hMPV
China Buka Suara ke WHO soal Gaduh Kenaikan Kasus hMPV Casino Online – Kementerian luar negeri China telah berkomunikasi erat bersama Organisasi Kesehatan Dunia (WHO) berkenaan penyakit pernapasan human metapneumovirus (hMPV). Dalam konferensi pers rutin, juru bicara kementerian luar negeri Guo Jiakun mengatakan pemerintah China amat menyimak kesehatan rakyat dan warga asing yang ada di […]
asil Liga 1: 10 Pemain Persib Tahan PSBS 1-1
asil Liga 1: 10 Pemain Persib Tahan PSBS 1-1 Live Poker Indonesia – 10 pemain Persib Bandung mampu menghindar PSBS Biak 1-1. Maung Bandung masih melindungi catatan helium terkalahkan di musim ini. PSBS Biak vs Persib Bandung terhadap laga kelanjutan Liga 1 berlangsung di Stadion Lukas Enembe, Papua, Sabtu (11/1/2025). Saling serang berlangsung di babak […]
aarten Paes Menanti Bulan Maret yang Menantang
aarten Paes Menanti Bulan Maret yang Menantang Bandar Togel Online Terbaik – Lanjutan ronde ketiga Kualifikasi Piala Dunia 2026 di Maret mendatang, Timnas Indonesia dapat hadapi Australia dan Bahrain. Maarten Paes bersiap menyambutnya! Timnas Indonesia selagi duduk di peringkat ketiga Grup C ronde ketiga Kualifikasi Piala Dunia 2026 Zona Asia. Garuda mengoleksi enam poin, tertinggal […]
Balas Dendam: Geisha’s Revenge Membawa Jackpot Menggunung
Balas Dendam: Geisha’s Revenge Membawa Jackpot Menggunung Balas Dendam: Geisha’s Revenge Membawa Jackpot Menggunung Game Geisha’s Revenge membawa rencana yang amat unik ke dunia Slot Server Tiongkok. Terinspirasi oleh kisah balas dendam seorang geisha, permainan ini menghadirkan situasi yang penuh emosi dan intensitas. Dengan latar belakang budaya Jepang yang kaya, game ini tidak cuma menarik […]
Rio Fantasia: Karnaval Penuh Warna dan Kegembiraan Hadiah
Rio Fantasia: Karnaval Penuh Warna dan Kegembiraan Hadiah Rio Fantasia adalah game slot yang terinspirasi oleh kemeriahan karnaval Rio de Janeiro. Game ini mempunyai pemain ke situasi festival penuh warna bersama musik samba yang riang dan lambang yang mencerminkan stimulus pesta. Dengan fitur permainan yang inovatif dan visual yang memukau, Rio Fantasia tawarkan pengalaman bermain […]
Strategi Bermain Slot Arcane Elements berasal dari Habanero
Strategi Bermain Slot Arcane Elements berasal dari Habanero Dalam dunia permainan slot online, Arcane Elements berasal dari Habanero telah jadi salah satu pilihan terkenal bagi para pemain yang tertarik bersama dengan tema magis dan elemen-elemen alam. Slot ini menawarkan pengalaman bermain yang mendalam bersama dengan desain visual yang menarik dan fitur-fitur bonus yang dapat menaikkan […]
Game Gemstones Gold Gacor berasal dari PG Soft
Game Gemstones Gold Gacor berasal dari PG Soft Gemstones Gold adalah game slot video berasal dari PG Soft yang memukau secara visual, tawarkan mekanisme pay anywhere yang unik dan RTP tinggi sebesar 96,71%. Dengan potensi kemenangan maksimum sampai 7.500x taruhan kamu, slot ini sesuai untuk pemain bersama beragam anggaran. Desainnya yang terdiri berasal dari 6 […]
Langkah-langkah Mudah Dapatkan Scatter Candy Jar Clusters
Langkah-langkah Mudah Dapatkan Scatter Candy Jar Clusters Langkah-langkah Mudah Dapatkan Scatter Candy Jar Clusters. Candy Jar Clusters adalah keliru satu permainan slot online yang terlampau populer dikarenakan tema yang menggembirakan dan fitur-fitur menariknya hanya di cnnslot. Salah satu elemen penting didalam permainan ini adalah lambang scatter, yang berfungsi untuk menyebabkan putaran bonus dan tingkatkan kesempatan […]